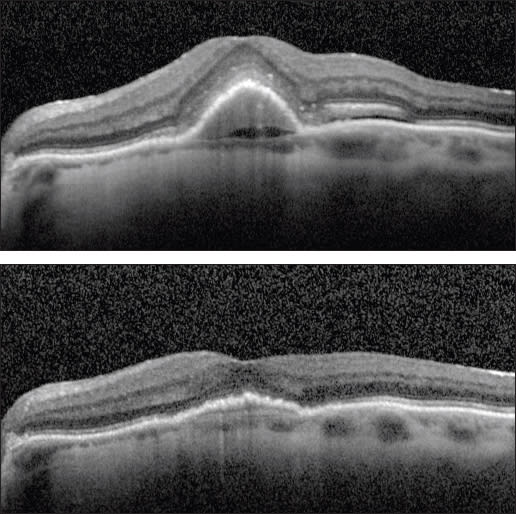
images
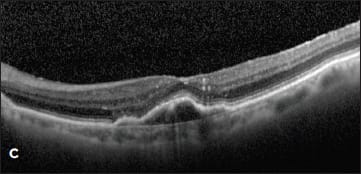
images

Pigment epithelial detachment (PED) is a pathological process in which the retinal pigment epithelium separates from the underlying Bruch’s membrane due to the presence of blood, serous exudate, drusen, or a neovascular membrane.1 The various subtypes of PEDs can be classified based on their appearance according to ophthalmoscopic, tomographic, and angiographic characteristics.2
Pigment epithelial detachments can occur idiopathically or in association with AMD, central serous chorioretinopathy (CSC), angioid streaks, presumed ocular histoplasmosis syndrome (POHS), or hereditary chorioretinal degenerations. This review will focus on the vascularized PEDs found in association with neovascular AMD.
The pathogenesis of PED formation in AMD is not completely understood, but it is believed to be due to the growth of choroidal neovascularization through Bruch’s membrane into the sub-RPE space with secondary extravasation of fluid or blood.3
Clinically, PEDs appear as domed elevations of the RPE layer and may be associated with other signs of AMD, including drusen, overlying RPE hyperpigmentation, subretinal fluid, or subretinal hemorrhage. On OCT imaging, a PED is identified when a space is formed between the RPE and Bruch’s membrane. This space can be filled with a moderately hyper-reflective material in a druesnoid PED or show mixed hyper- and hypo-reflectivity consistent with the vascular and exudative component of a CNV in a fibrovascular or serous PED. In the presence of an active CNV, the PED may be associated with a small buttress of subretinal fluid along its base and intraretinal or subretinal fluid. Classically, on fluorescein angiography, pooling is seen within the PED, often with a central dimple or peripheral notch that corresponds to the CNV membrane.
In AMD, PEDs are important markers of disease severity, risk for progression, and vision loss. PEDs are seen in up to 62% of eyes with advanced AMD,4 and approximately 50% of patients with newly diagnosed PEDs will experience significant visual loss (>3 lines) one year from diagnosis.5
TREATMENT WITH ANTI-VEGF AGENTS
The advent of anti-VEGF therapy in the past decade has revolutionized the treatment of neovascular AMD. Despite the widespread success of anti-VEGF therapy in resolving the subretinal and intraretinal fluid associated with CNV, PEDs are often highly resistant to treatment.6-9
Limited prospective data are available to guide treatment for PEDs. Large landmark clinical trials (ANCHOR, MARINA, PIER, CATT, EXCITE) either excluded patients with large PEDs, or if they were included in the patient cohort (ie, fibrovascular PEDs as part of occult CNV), then the subanalyses did not report the PED response to treatment.10-14 Consequently, the results of these large trials cannot be directly extropolated for treatment of PEDs in neovascular AMD.
The smaller PRONTO study evaluated the efficacy of OCT-guided as-needed dosing of intravitreal ranibizumab for neovascular AMD, and it included an analysis of PED response to treatment.15 At one year, the study reported a strong correlation between decreased central retinal thickness and increased BCVA in patients with and without PEDs.
The study also highlighted the resistance of PEDs to anti-VEGF therapy compared to subretinal fluid and intraretinal fluid. In a subgroup analysis, the authors reported that 29 (73%) eyes had a PED at baseline, of which 14 (42%) resolved at one year.15 In the remaining 15 eyes, the PEDs persisted but showed some decrease in size.
In contrast, cystic changes were present in 36 eyes at baseline, and these changes resolved in 30 eyes (83%) within seven days. Overall, the improvement in vision with ranibizumab therapy was correlated with resolution of SRF/IRF and central retinal thickness, rather than with resolution of PEDs.15
The findings from PRONTO have been mirrored in several smaller retrospective studies and case reports focused specifically on eyes with PEDs.16-18 These studies have reported a similar improvement in BCVA after anti-VEGF therapy that was correlated with decreased thickness in the overlying neurosensory retina, rather than with PED flattening.
Lommatzsch et al. retrospectively reviewed 328 patients with serous PEDs associated with neovascular AMD and treated with intravitreal anti-VEGF agents and photodynamic therapy.17 The authors observed a significant improvement in vision and retinal thickness after injection of bevacizumab or ranibizumab compared to pegaptanib sodium alone or combined treatment with intravitreal triamcinolone acetonide and PDT.17 Although PED height decreased after treatment with anti-VEGF agents, the visual acuity improvement was correlated directly with the improvement in central foveal thickness.17
In another smaller study, patients with vascularized (CNV noted by FA) and avascular (no CNV noted on FA) PEDs were treated with serial intravitreal ranibizumab injections.16 Once again, treatment improved vision in 65% of patients, but in no cases did the PEDs resolve completely.16 In contrast, some smaller studies have even suggested a negative impact on BCVA, even with anatomic PED flattening.7,9 However, the high occurrence of RPE rips may have influenced the poor visual outcomes in these studies.7
Figure 1. (top) A patient with a new occult CNV with PED and subretinal fluid was treated with two monthly intravitreal injections of ranibizumab with flattening of the PED and resolution of the SRF (bottom).
The majority of evidence to date has suggested the maximum benefit to BCVA is obtained by resolution of cystic and subretinal fluid and that PEDs are typically very resistant to conventional anti-VEGF therapy. Thus, the consensus treatment follows the PRONTO guidelines and recommends continuing treatment or retreating for IRF, SRF, decreased vision, or significant growth of the PED, but the guidelines allow for observation of a stable PED.
Regardless of possible anti-VEGF resistance by PEDs, the best available initial therapy for patients with new neovascular AMD remains an intravitreal anti-VEGF agent. PED flattening has been reported with bevacizumab and ranibizumab, which, despite these drugs’ varied effects on BCVA, still suggests a desired level of control over neovascular disease activity.6,19 In some cases, patients will respond well to the first anti-VEGF agent employed; in others, attempting multiple agents may be necessary to achieve anatomic or visual response, or both.
Case Studies
Case 1. This case involved a 92-year-old woman who presented with a new occult lesion in the left eye. Prior to her conversion, her baseline vision was 20/40. Despite new CNV with a PED and subretinal fluid noted on OCT, her vision remained unchanged (Figure 1). She was treated twice with intravitreal ranibizumab with dramatic resolution of the PED and subretinal fluid.
Most patients, however, will require multiple injections to control disease activity. Some patients will respond to a new agent when they have failed previous therapy.
Case 2. The second case involved a 99-year-old woman who presented with a new occult lesion in the left eye. There was loss of one line of vision at 20/40, and a new PED with associated subretinal fluid was noted on her OCT (Figure 2A). She was treated with three doses of monthly bevacizumab with a minimal response, and her vision declined to 20/50+2 (Figure 2B).
She was then switched to monthly ranibizumab. The subretinal fluid resolved with one injection, and her vision improved to 20/30. However, after nine injections of monthly ranibizumab, her vision declined to 20/40, with a small amount of intraretinal fluid and an enlarging PED (Figure 2C). This visit coincided with the commercially availability of aflibercept, and the treatment was changed to monthly 2.0 mg aflibercept. After two injections, her vision improved to 20/30, the PED flattened, and the subretinal fluid resolved (Figure 2D).
Our experience with this patient may be suggestive of an emerging benefit of aflibercept, as evidenced by the multiple abstracts presented at the 2012 meeting of the American Society of Retinal Specialists meeting, which reported PED improvement or resolution in patients who had failed therapy prior to treatment with aflibercept.20,21
PDT WITH VERTEPORFIN
Photodynamic therapy with verteporfin was a standard treatment for neovascular AMD before anti-VEGF therapy was available.22,23 It has been re-evaluated as a potential adjunct to reduce the number of anti-VEGF treatments required for disease control and as therapy for the AMD variant polypoidal choroidal vasculopathy (PCV).
Three large, prospective, randomized, controlled trials were initiated as part of the SUMMIT clinical trial program to study the safety and efficacy of verteporfin/PDT in combination with ranibizumab in the treatment of sub-foveal CNV associated with AMD (MONT BLANC and DENALI)24,25 and PCV (EVEREST).26
However, patients with PEDs were excluded from the MONT BLANC and DENALI studies. PEDs were not part of the exclusion criteria in EVEREST, but the study did not report a subgroup analysis of the response of PEDs to therapy. MONT BLANC and DENALI failed to find an increased treatment-free interval with combined therapy, but EVEREST did report that at six months, combination PDT and ranibizumab was superior in achieving polyp regression by indocyanine green angiography.

Figure 2. A new occult CNV with PED (A). After treatment with bevacizumab, OCT showed persistent subretinal fluid (B). The therapy was switched to ranibizumab, and after nine injections, the PED had slightly grown in size, but the subretinal fluid had resolved (C). Due to PED growth, the patient was switched to aflibercept, and after two injections, the subretinal fluid resolved, and the PED flattened (D).
Several smaller, mostly retrospective studies are the main sources of evidence regarding the efficacy of PDT for PEDs. Some studies used PDT alone,27-29 in combination with intravitreal triamcinolone,7 or with intravitreal bevacizumab (Avastin, Genentech, South San Francisco, Calif.).30,31 Overall, they failed to demonstrate a robust effect on PED anatomy or match the BCVA outcomes provided by anti-VEGF therapy.




Figure 3. A patient with a new serous PED and CNV identified by ICG was treated with ranibizumab, followed by monthly aflibercept (A and B). Despite treatment, the PED worsened with increasing size and SRF (C). The patient then underwent PDT to the area of the choroidal feeder vessel without resolution (D).




Figure 4. A patient with a new CNV seen on FA was treated with ranibizumab (A). The large serous PED failed to resolve (B). A focal lesion was noted at 1 o’clock by ICG (C) and was treated with PDT. The PED flattened with improved BCVA (D).
However, there continues to be considerable interest in PDT as a treatment modality for patients with PEDs associated with PCV, as well as in select cases of neovascular AMD with extrafoveal lesions or feeder vessels that can be localized by ICG angiography.
Case Studies
Case 3. A 78-year-old woman presented with new neovascular AMD with a PED in the right eye (Figures 3A and B). Her vision dropped from 20/25 to 20/50. After multiple treatments with ranibizumab, the PED persisted, and her vision declined to 20/80. ICG angiography was performed, and a hot spot was identified at 1 o’clock (Figure 3C). This spot was treated with PDT, with collapse of the PED and BCVA improvement to 20/32 (Figure 3D).
Despite this success, many patients with PEDs will not respond to combination therapy.
Case 4. Such was the case of a 56-year-old woman who presented with a large serous PED with small amount of subretinal fluid (Figure 4A). Her vision had dropped from 20/20 to 20/400. Fluorescein angiography revealed a notch at the inferior-temporal border of the PED. ICG angiography showed a large, dilated vessel at 7 o’clock (Figure 4B).
The patient was treated with intravitreal aflibercept without improvement and then was switched to intravitreal ranibizumab. Despite treatment, the PED grew in size, and the subretinal fluid increased (Figure 4C). She was re-evaluated with ICG angiography (Figure 4D), and then was treated with PDT to the area of the choroidal vessel identified at 7 o’clock.

Figure 5. A patient with a serous PED was observed at presentation (A) and developed subretinal fluid three months later (B). Treatment was offered at three months, but the patient declined until a PED developed in the fellow eye 13 months later (C). At that time, the patient underwent intravitreal treatment with bevacizumab, with resolution of the subretinal fluid and a decrease in height of the PED (D). The patient’s vision was 20/32 both before and after treatment.
Four months later, the PED was unchanged, and she was retreated with PDT in combination with her monthly aflibercept. One month after the second PDT, her vision and exam remained unchanged.
There remains an absence of high-caliber evidence to guide the use of PDT in patients with PEDs. However, for patients who fail to respond to the available anti-VEGF agents, who have worsening disease, or who are functionally impaired by a large PED, ICG angiography-guided PDT of extrafoveal lesions can be an effective treatment option.
A COMPLICATION OF THERAPY: RPE TEARS
Tears or rips of the RPE are a rare, but potentially vision-threatening, complication in the natural history of PEDs, which can occur spontaneously or after treatment. RPE tears have been described after treatment with intravitreal anti-VEGF agents,32,33 PDT,34,35 or laser photocoagulation.36-38
The pathogenic mechanisms of RPE tears are not completely understood, but they are thought to involve tangential shear forces within the RPE that cause dehiscence and separation of the epithelial basement membrane. This may be a result of contraction of underlying CNV.1 RPE mounding and adjacent RPE atrophy are clinical hallmarks of this condition.
The rate of RPE tears in patients with PEDs is controversial. One large, retrospective series reported the rate of spontaneous RPE tears in patients with PEDs of all subtypes at 3%.39 A slightly higher rate of 11.9% has been reported for serous PEDs.5
Retinal pigment epithelium tears have also been reported after treatment with anti-VEGF agents, including bevacizumab, ranibizumab, and pegaptanib, at a rate of 16.8% to 26.2% depending on the size and type of PED involved.7,40,41 The rate of RPE tears after PDT may be even higher, ranging from 13%35 to 40.6%.7
Most RPE tears occur within several weeks of treatment. Large PEDs appear to be at the greatest risk for tears. Central PED height, PED volume, and the presence of subretinal fluid have been identified as potential risk factors for an RPE tear.40 The severity of visual loss is correlated with the size and location of the RPE tear.
Tears greater than 1 disc diameter and those involving the fovea are at the greatest risk for severe vision loss and are least likely to respond to subsequent anti-VEGF therapy. Conversely, eyes with smaller RPE tears located away from the fovea have better prognoses. If they are associated with subretinal fluid, they may still respond to additional anti-VEGF therapy with visual improvement.
Case Study
Case 5. The desire to avoid the risk of an RPE tear led one patient to refuse anti-VEGF therapy for more than a year and a half. This 69-year-old man presented with a large serous PED in the right eye, resulting in decreased vision from 20/20 to 20/126 (Figure 5A). There was no associated intraretinal or subretinal fluid on OCT, and due to the ability to correct his vision comfortably with a hyperopic refraction, observation with close follow-up was chosen.
Three months later, his vision remained 20/32, but subretinal fluid was noted on OCT (Figure 5B). Treatment was recommended, but the patient refused therapy. On multiple return visits, the patient continued to decline treatment. Sixteen months after his initial presentation, he developed metamorphopsia in his left eye, and a new serous PED was seen on OCT. The PED in his right eye had a stable cuff of subretinal fluid (Figure 5C).
At this point the patient consented to treatment with intravitreal bevacizumab in the right eye. After three injections, the subretinal fluid resolved, and the PED decreased slightly in apical height (Figure 5D). His vision remained unchanged at 20/32 throughout treatment.
CONCLUSIONS
In summary, PEDs represent a significant cause of visual morbidity in patients with neovascular AMD, and despite the efficacy of current therapies, PEDs remain a significant treatment challenge. Progression despite treatment and vision-threatening complications, including RPE tears, only adds to the complexity of managing this manifestation of AMD.
We will closely observe new serous PEDs that do not produce vision loss and are not associated with retinal thickening, hemorrhage, or subretinal fluid. If any progression is noted, we recommend anti-VEGF therapy, with close monitoring by OCT and fluorescein angiography. Collapse of the PED, in the setting of stable vision and anatomy, is not the primary goal of therapy. Future studies are needed to address these challenges and improve patient outcomes.
|
Bozho Todorich, MD, PhD, is a resident in ophthalmology at the Duke University Eye Center in Durham, NC. Kathryn Pepple, MD, PhD, is a medical retina fellow at the Duke University Eye Center. Prithvi Mruthyunjaya, MD, is associate professor of ophthalmology at the Duke University Eye Center. None of the authors reports any financial interests in any products mentioned in this article. Dr. Mruthyunjaya can be reached via e-mail at prithvi.m@duke.edu. |
REFERENCES
1. Gass JD. Pathogenesis of tears of the retinal pigment epithelium. Br J Ophthalmol. 1984;68:513-519.
2. Pepple K, Mruthyunjaya P. Retinal pigment epithelial detachments in age-related macular degeneration: classification and therapeutic options. Semin Ophthalmol. 2011;26:198-208.
3. Gass JD. Serous retinal pigment epithelial detachment with a notch. A sign of occult choroidal neovascularization. Retina. 1984;4:205-220.
4. Coscas F, Coscas G, Souied E, Tick S, Soubrane G. Optical coherence tomography identification of occult choroidal neovascularization in age-related macular degeneration. Am J Ophthalmol. 2007;144:592-599.
5. Pauleikhoff D, Löffert D, Spital G, et al. Pigment epithelial detachment in the elderly. Clinical differentiation, natural course and pathogenetic implications. Graefes Arch Clin Exp Ophthalmol. 2002;240:533-538.
6. Freeman WR, Kozak I, Yuson RM, Nigam N, Cheng L, Mojana F. Prognostic implications of pigment epithelial detachment in bevacizumab (avastin)-treated eyes with age-related macular degeneration and choroidal neovascularization. Retina. 2011;31:1812-1818.
7. Introini U, Torres Gimeno A, Scotti F, Setaccioli M, Giatsidis S, Bandello F. Vascularized retinal pigment epithelial detachment in age-related macular degeneration: treatment and RPE tear incidence. Graefes Arch Clin Exp Ophthalmol. 2012;250:1283-1292.
8. Ritter M, Bolz M, Sacu S, et al. Effect of intravitreal ranibizumab in avascular pigment epithelial detachment. Eye (Lond). 2010;24:962-968.
9. Akinwale AFM, Vasquez V, Husain D. Ranibizumab monotherapy in neovascular age-related macular degeneration with pigment epithelial detachment. J Clin Exp Ophthalmol. 2011;2:1000199.
10. CATT Research Group; Martin DF, Maguire MG, Ying GS, Grunwald JE, Fine SL, Jaffe GJ. Ranibizumab and bevacizumab for neovascular age-related macular degeneration. N Engl J Med. 2011;364:1897-1908.
11. Rosenfeld PJ, Brown DM, Heier JS, et al.; MARINA Study Group. Ranibizumab for neovascular age-related macular degeneration. N Engl J Med. 2006; 355:1419-1431.
12. Regillo CD, Brown DM, Abraham P, et al. Randomized, double-masked, sham-controlled trial of ranibizumab for neovascular age-related macular degeneration: PIER Study year 1. Am J Ophthalmol. 2008;145:239-248.
13. Schmidt-Erfurth U, Eldem B, Guymer R, et al.; EXCITE Study Group. Efficacy and safety of monthly versus quarterly ranibizumab treatment in neovascular age-related macular degeneration: the EXCITE study. Ophthalmology.2011; 118:831-839.
14. Brown DM, Kaiser PK, Michels M, et al.; ANCHOR Study Group. Ranibizumab versus verteporfin for neovascular age-related macular degeneration. N Engl J Med. 2006;355:1432-1444.
15. Fung AE, Lalwani GA, Rosenfeld PJ, et al. An optical coherence tomography-guided, variable dosing regimen with intravitreal ranibizumab (Lucentis) for neovascular age-related macular degeneration. Am J Ophthalmol. 2007; 143:566-583.
16. Arora S, McKibbin M. One-year outcome after intravitreal ranibizumab for large, serous pigment epithelial detachment secondary to age-related macular degeneration. Eye (Lond). 2011;25:1034-1038.
17. Lommatzsch A, Heimes B, Gutfleisch M, Spital G, Zeimer M, Pauleikhoff D. Serous pigment epithelial detachment in age-related macular degeneration: comparison of different treatments. Eye (Lond). 2009;23:2163-2168.
18. Arias L. Treatment of retinal pigment epithelial detachment with antiangiogenic therapy. Clin Ophthalmol. 2010;4:369-374.
19. Chan CK, Abraham P, Sarraf D. High-dose ranibizumab therapy for vascularized pigment epithelial detachment. Eye (Lond). 2012;26:882-885.
20. Major J. Pigment epithelial detachment improvement in non-naive neovascular AMD patients after intravitreal aflibercept. Paper presented at: Annual Meeting of the American Society of Retinal Specialists; Las Vegas, NV; August 27, 2012.
21. Sharma A. Resolution of persistent macular edema, SRF, and/or RPE detachment after single injection of aflibercept in Patients with neovascular ARMD. Paper presented at: Annual Meeting of the American Society of Retinal Specialists; Las Vegas, NV; August 27, 2012.
22. Photodynamic therapy of subfoveal choroidal neovascularization in age-related macular degeneration with verteporfin: one-year results of 2 randomized clinical trials—TAP report. Treatment of age-related macular degeneration with photodynamic therapy (TAP) Study Group. Arch Ophthalmol. 1999; 117:1329-1345.
23. Verteporfin In Photodynamic Therapy Study Group. Verteporfin therapy of subfoveal choroidal neovascularization in age-related macular degeneration: two-year results of a randomized clinical trial including lesions with occult with no classic choroidal neovascularization—verteporfin in photodynamic therapy report 2. Am J Ophthalmol. 2001;131:541-560.
24. Kaiser PK, Boyer DS, Cruess AF, Slakter JS, Pilz S, Weisberger A; DENALI Study Group. Verteporfin plus ranibizumab for choroidal neovascularization in age-related macular degeneration: twelve-month results of the DENALI study. Ophthalmology. 2012;119:1001-1010.
25. Larsen M, Schmidt-Erfurth U, Lanzetta P, et al.; MONT BLANC Study Group. Verteporfin plus ranibizumab for choroidal neovascularization in age-related macular degeneration: twelve-month MONT BLANC study results. Ophthalmology. 2012;119:992-1000.
26. Koh A, Lee WK, Chen LJ, et al. EVEREST STUDY: Efficacy and safety of verteporfin photodynamic therapy in combination with ranibizumab or alone versus ranibizumab monotherapy in patients with symptomatic macular polypoidal choroidal vasculopathy. Retina. 2012;32:1453-1464.
27. Axer-Siegel R, Ehrlich R, Rosenblatt I, et al. Photodynamic therapy for occult choroidal neovascularization with pigment epithelium detachment in age-related macular degeneration. Arch Ophthalmol. 2004;122:453-459
28. Pece A, Isola V, Vadala M, Calori G. Photodynamic therapy with verteporfin for choroidal neovascularization associated with retinal pigment epithelial detachment in age-related macular degeneration. Retina.2007;27:342-348.
29. Coscas F, Stanescu D, Coscas G, Soubrane G. [Feeder vessel treatment of choroidal neovascularization in age-related macular degeneration]. J Fr Ophtalmol. 2003;26:602-608.
30. Shima C, Gomi F, Sawa M, Sakaguchi H, Tsujikawa M, Tano Y. One-year results of combined photodynamic therapy and intravitreal bevacizumab injection for retinal pigment epithelial detachment secondary to age-related macular degeneration. Graefes Arch Clin Exp Ophthalmol. 2009;247:899-906.
31. Ladas ID, Kotsolis AI, Papakostas TD, Rouvas AA, Karagiannis DA, Vergados I. Intravitreal bevacizumab combined with photodynamic therapy for the treatment of occult choroidal neovascularization associated with serous pigment epithelium detachment in age-related macular degeneration. Retina. 2007; 27:891-896.
32. Gamulescu MA, Framme C, Sachs H. RPE-rip after intravitreal bevacizumab (Avastin) treatment for vascularised PED secondary to AMD. Graefes Arch Clin Exp Ophthalmol. 2007;245:1037-1040.
33. Subramanyam A, Phatak S, Chudgar D. Large retinal pigment epithelium rip following serial intravitreal injection of avastin in a large fibrovascular pigment epithelial detachment. Indian J Ophthalmol. 2007;55:483-486.
34. Gelisken F, Inhoffen W, Partsch M, Schneider U, Kreissig I. Retinal pigment epithelial tear after photodynamic therapy for choroidal neovascularization. Am J Ophthalmol. 2001;131:518-520.
35. Pece A, Introini U, Bottoni F, Brancato R. Acute retinal pigment epithelial tear after photodynamic therapy. Retina. 2001;21:661-665.
36. Gass JD. Retinal pigment epithelial rip during krypton red laser photocoagulation. Am J Ophthalmol. 1984;98:700-706.
37. Thompson JT. Retinal pigment epithelial tear after transpupillary thermotherapy for choroidal neovascularization. Am J Ophthalmol. 2001;131:662-664.
38. Yeo JH, Marcus S, Murphy RP. Retinal pigment epithelial tears. Patterns and prognosis. Ophthalmology . 1988;95:8-13.
39. Hartnett ME, Weiter JJ, Garsd A, Jalkh AE. Classification of retinal pigment epithelial detachments associated with drusen. Graefes Arch Clin Exp Ophthalmol. 1992;230:11-19.
40. Chan CK, Abraham P, Meyer CH, et al. Optical coherence tomography-measured pigment epithelial detachment height as a predictor for retinal pigment epithelial tears associated with intravitreal bevacizumab injections. Retina. 2010;30:203-211.
41. Kook D, Wolf A, Neubauer AS, et al. [Retinal pigment epithelial tears after intravitreal injection of bevacizumab for AMD. Frequency and progress]. Ophthalmologe. 2008;105:158-164.








